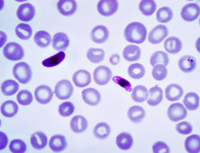
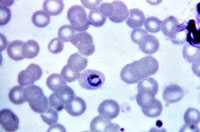

Kiểm tra tình hình thực tế tại cơ sở, nhất là các điểm kính hiển vi ở tuyến xã, thị trấn miền núi. Các xét nghiệm viên không sử dụng dung dịch đệm có độ pH 7,2 để pha giemsa nhuộm lam máu mà chỉ dùng nguồn nước sẵn có như nước tự chảy, nước suối , nước giếng, nước máy ... có độ pH không thích hợp. Vấn đề này đã làm ảnh hưởng đến chất lượng nhuộm lam máu và xét nghiệm phát hiện ký sinh trùng sốt rét.
Thực trạng tình hình
Trung tâm Phòng chống Sốt rét-Ký sinh trùng-Côn trùng tỉnh Thừa Thiên Huế tiến hành kiểm tra 36 điểm kính hiển vi của 9 đơn vị huyện, thị xã, thành phố và quân y biên phòng ghi nhận hầu hết không sử dụng dung dịch đệm có độ pH chuẩn 7,2 để pha dung dịch giemsa nhuộm lam máu phát hiện ký sinh trùng sốt rét mà chỉ sử dụng các nguồn nước tự nhiên sẵn có tại cơ sở. Phần lớn xét nghiệm viên đã sử dụng 38,89% nước máy; 38,89% nước giếng; 16,67% nước tự chảy và 5,56% nước suối để pha dung dịch nhuộm giemsa. Qua 36 mẫu nước được khảo sát bằng máy EcoScan đo độ pH, tất cả các mẫu nước đều có độ pH từ 7,0 trở xuống; không có nguồn nước nào bảo đảm đúng độ pH 7,2. Vấn đề này đã làm ảnh hưởng đến chất lượng lam máu nhuộm giemsa nên khi soi kính hiển vi bị hạn chế trong việc phát hiện đầy đủ hình thể của các chủng loại ký sinh trùng sốt rét. Đứng trước thực trạng tình hình này, tuyến tỉnh đã chỉ đạo cho các cơ sở thực hiện đúng quy trình kỹ thuật chuẩn theo quy định của Tổ chức Y tế Thế giới (WHO).
Dung dịch đệm có độ pH 7,2
Dung dịch đệm có độ pH chuẩn 7,2 đã được các nhà sản xuất cung cấp bán trên thị trường theo những loại hóa chất xét nghiệm khác. Nếu có điều kiện, nên mua loại dung dịch đệm chuẩn này cấp cho các điểm kính hiển vi sử dụng cùng với hoá chất giemsa, dầu soi, xylen... Nếu không có điều kiện, xét nghiệm viên có thể tự pha dung dịch đệm với yêu cầu phải có các hóa chất cần thiết.
Pha dung dịch đệm bằng cách lấy một gói Dinatri hydrogene phosphate ngậm 12 phân tử nước (Na2HPO4.12H2O) loại 2,5g và một gói Kali hydrogene phosphate (KH2PO4) loại 0,7g cho vào 1.000 ml (1 lít) nước cất hoặc nước mưa, nước máy sạch. Dùng đũa thủy tinh khuấy cho tan rồi dùng máy đo pH hoặc giấy thử pH để thử. Nếu độ pH = 7,2 là đạt yêu cầu. Nếu độ pH dưới 7,2 thì dùng dung dịch Dinatri hydrogene phosphate (Na2HPO412H2O) 2% để điều chỉnh đến khi đạt độ pH = 7,2. Nếu độ pH trên 7,2 thì dùng dung dịch Kali hydrogene phosphate (KH2PO4) 2% để điều chỉnh đến khi đạt độ pH = 7,2. Dung dịch được bảo quản nơi thoáng mát, tránh ánh sáng. Hạn sử dụng dung dịch đệm đã pha chỉ dùng trong 3 tuần.
Khi dung dịch đệm đã pha không đạt yêu cầu với độ pH = 7,2; phải dùng dung dịch điều chỉnh như Na2HPO4.12H2O 2% hoặc KH2PO4 2% như đã nói ở trên. Muốn pha dung dịch điều chỉnh, lấy một gói Na2HPO4.12H2O loại 2g cho vào 100 ml nước cất hoặc nước mưa, nước máy sạch, khuấy cho tan thì được dung dịch Na2HPO412H2O 2%. Tương tự như vậy, lấy một gói KH2PO4 loại 2g cho vào 100 ml nước cất hoặc nước mưa, nước máy sạch, khuấy cho tan thì được dung dịch KH2PO4 2%. Dung dịch được bảo quản nơi thoáng mát, tránh ánh sáng. Hạn sử dụng dung dịch điều chỉnh đã pha chỉ dùng trong 3 tháng.
Cách thử và điều chỉnh độ pH được theo dõi bằng giấy thử đơn giản. Dùng dung dịch đệm định thử cho vào cốc thủy tinh, lấy một đoạn giấy thử pH đặt lên một lam kính; nên sử dụng loại giấy thử pH tốt nhất và dùng kẹp y tế để kẹp giấy, không được cầm trực tiếp bằng 2 ngón tay. Tiếp theo, dùng pipette hút dung dịch đệm trong cốc, nhỏ giọt vào băng giấy thử cho thấm đều vừa đủ, không nhỏ quá nhiều để nước tràn ra. Lấy phiến kính có chứa đoạn giấy thử lên và đem so màu với màu ở thang độ pH mẫu gắn trên hộp giấy thử để đọc kết quả. Nếu độ pH dung dịch đệm đạt màu ở mức pH 7,2 là đạt yêu cầu. Nếu độ pH dung dịch đệm đạt ở mức trên 7,2 thì dùng pipette nhỏ từ từ dung dịch KH2PO4 2% vào dung dịch đệm trong cốc đong rồi dùng giấy thử pH thử lại cho đến khi pH của dung dịch đệm đạt màu ở mức pH 7,2 là đạt yêu cầu. Nếu độ pH dung dịch đệm đạt ở mức dưới 7,2 thì dùng pipette nhỏ từ từ dung dịch Na2HPO4 2% vào dung dịch đệm trong cốc đong rồi dùng giấy thử pH thử lại cho đến khi pH của dung dịch đệm đạt màu ở mức 7,2 là đạt yêu cầu.
 |
Lấy lam máu xét nghiệm chẩn đoán sốt rét. |
Trong trường hợp không có dung dịch đệm, có thể sử dụng nước mưa sạch để pha thuốc nhuộm nhưng chỉ là tạm thời. Tốt nhất nên pha sẵn và có sẵn dung dịch đệm đạt chuẩn độ pH 7,2 để sử dụng. Ở các cơ sở y tế vùng cao, miền núi không có điều kiện pha dung dịch đệm, tuyến trên phải có trách nhiệm pha dung dịch hoặc mua dung dịch đệm đã được các nhà sản xuất pha sẵn để cung cấp. Đây được xem như là một biện pháp để nâng cao chất lượng phát hiện, chẩn đoán ký sinh trùng sốt rét ở các cơ sở; hạn chế những sai sót về xét nghiệm lam máu.
Cán bộ Khoa Dịch tễ của Viện Sốt rét-Ký sinh trùng-Côn trùng quy nhơn đang nhuộm lam máu tại labo và tại thực địa |
Độ pH dung dịch nhuộm liên quan màu sắc ký sinh trùng sốt rét và hồng cầu
Độ pH của dung dịch đệm dùng pha dung dịch giemsa nhuộm có liên quan đến sự bắt màu của ký sinh trùng sốt rét và hồng cầu bị nhiễm ký sinh trùng. Nếu độ pH dung dịch đệm đạt chuẩn 7,2 thì trên lam máu nhuộm giemsa, ký sinh trùng sốt rét có nhân bắt màu đỏ, nguyên sinh chất bắt màu xanh da trời, sắc tố bắt màu nâu đen hoặc màu nâu ánh vàng; hồng cầu bị ký sinh có màu hồng. Nếu độ pH dưới 7,2 thì màu sắc nhạt hơn và trên 7,2 thì màu sắc đậm hơn; không bảo đảm được màu sắc chuẩn khi soi phát hiện dưới kính hiển vi.
Để đánh giá một lam máu nhuộm đạt tiêu chuẩn cần căn cứ vào các yếu tố như vi trường phải sạch, không có cặn bẩn của giemsa; bạch cầu có nhân bắt màu tím đỏ, các hạt đặc hiệu rõ ràng, bạch cầu trung tính có các hạt bắt màu đỏ, hạch cầu ưa acide có các hạt bắt màu da cam. Ký sinh trùng sốt rét có nhân bắt màu đỏ, nguyên sinh chất bắt màu xanh da trời; hạt Schuffner và Maurer bắt màu hồng đỏ.
| |
Plasmodium vivax | Plasmodium falciparum |
 | |
Plasmodium malariae | Plasmodium ovale |
Một lam máu giọt mỏng đạt tiêu chuẩn nền lam máu sạch, không có vết bẩn, màu hồng cầu là màu xanh hồng nhạt; bạch cầu trung tính có màu tím đỏ và có các hạt đặc hiệu rõ ràng. Nhân của ký sinh trùng sốt rét có màu đỏ và nguyên sinh chất bắt màu xanh da trời. Có điểm những hạt Schuffner trong hồng cầu bị nhiễm Plasmodium vivax hoặc Plasmodium malariae; có những vết thô như vết Maurer trong hồng cầu bị nhiễm Plasmodium falciparum bắt màu đỏ hồng.
Một lam máu giọt dày đạt tiêu chuẩn khi hồng cầu phải được dung dải hết, bạch cầu có màu tím đỏ và có các hạt đặc hiệu rõ. Nhân của ký sinh trùng sốt rét có màu đỏ và nguyên sinh chất bắt màu xanh da trời.
Như vậy để nhuộm lam máu đạt tiêu chuẩn yêu cầu, giúp cho việc phát hiện, chẩn đoán ký sinh trùng một cách chính xác căn cứ vào các đặc điểm hình thể của ký sinh trùng bắt màu dung dịch nhuộm. Ngoài chất lượng dung dịch giemsa, độ pH 7,2 chuẩn của dung dịch đệm dùng pha dung dịch nhuộm cũng góp phần không nhỏ đến kết quả nhuộm lam máu xét nghiệm. Các điểm kính hiển vi cần quan tâm đến vấn đề này.